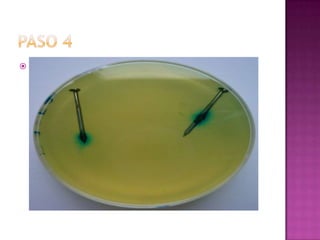
 Repite el mismo procedimiento anterior
colocando dentro del vaso numero 2 una
fibra humedecida con vinagre y en vaso 3
igual

La corrosión se define como el deterioro de un material a consecuencia de un ataque electroquímico por su entorno. Puede entenderse como la tendencia de los materiales a buscar su forma más estable. La velocidad de corrosión depende de factores como la temperatura, salinidad del fluido en contacto y las propiedades de los metales. El proceso de corrosión es natural y espontáneo.